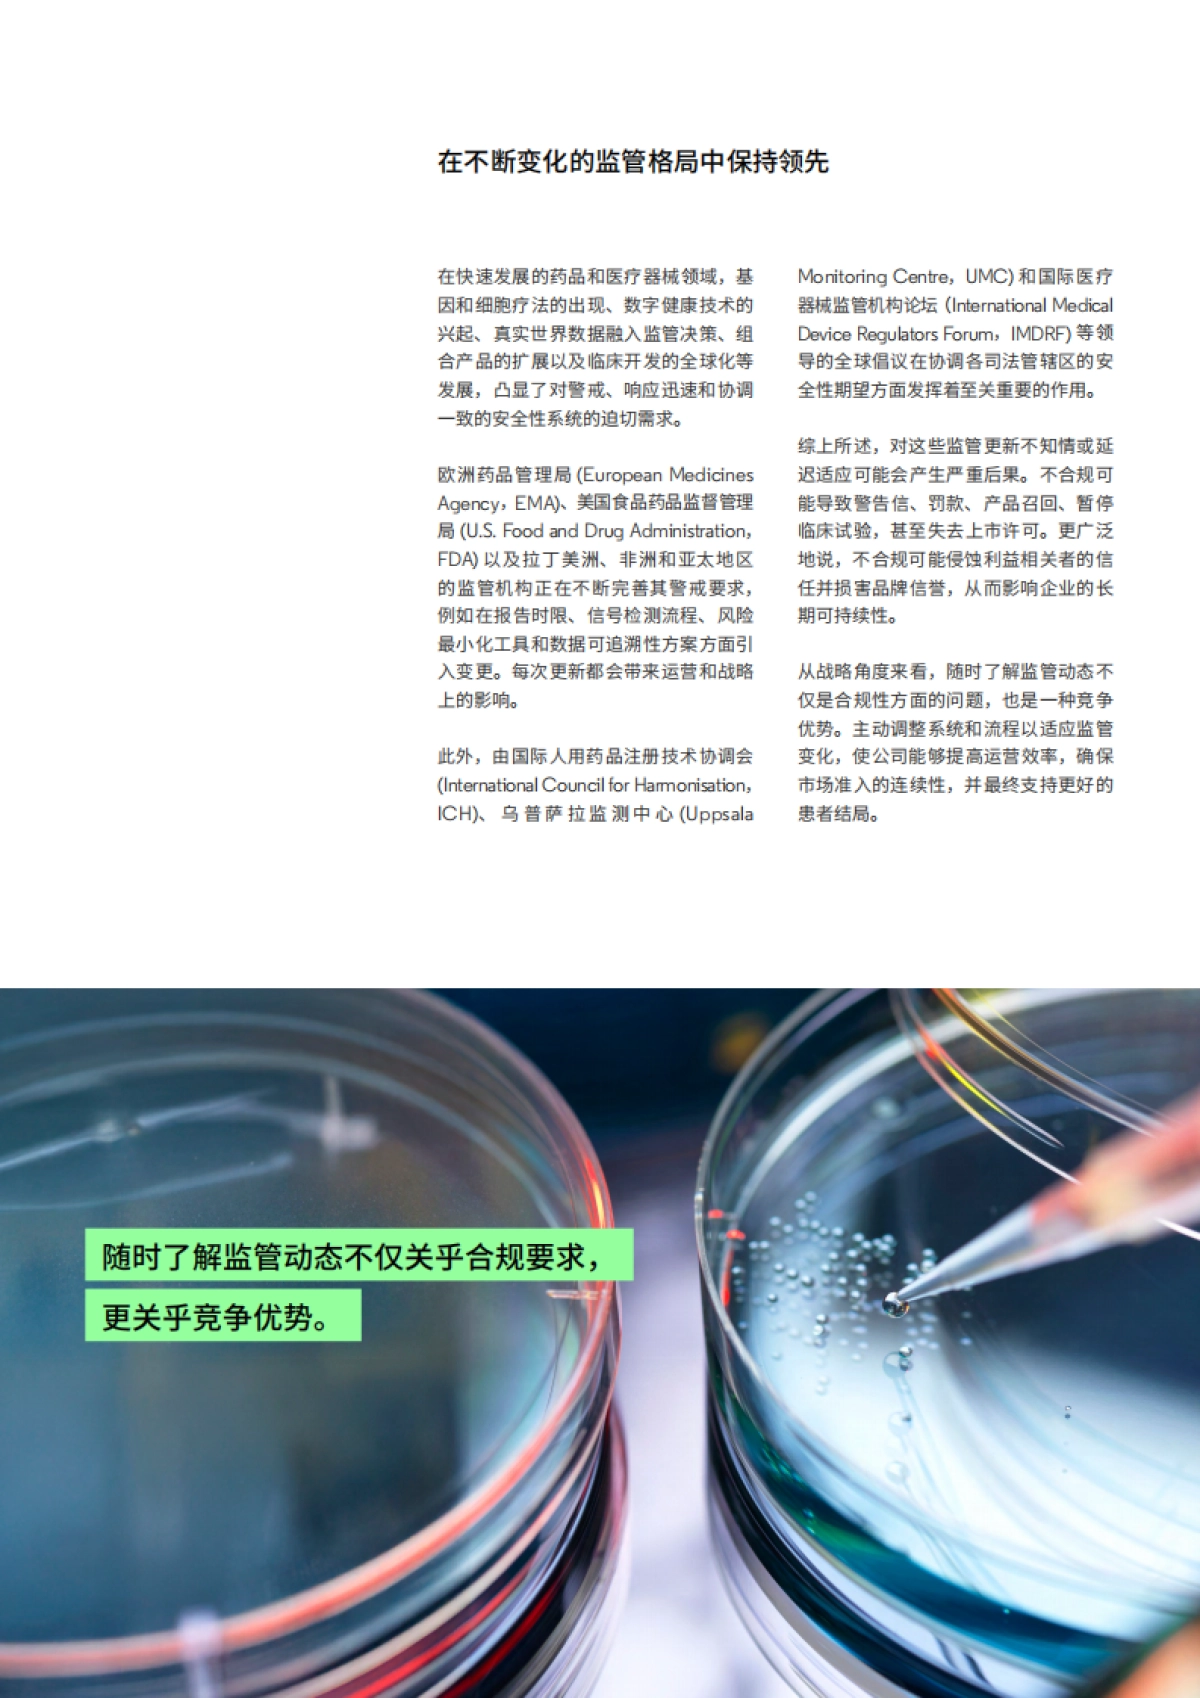
2025保持领先地位——药品和医疗器械警戒领域的前瞻性监管情报_第4页

1、当您付费下载文档后,您只拥有了使用权限,并不意味着购买了版权,文档只能用于自身使用,不得用于其他商业用途(如 [转卖]进行直接盈利或[编辑后售卖]进行间接盈利)。
2、本站所有内容均由合作方或网友上传,本站不对文档的完整性、权威性及其观点立场正确性做任何保证或承诺!文档内容仅供研究参考,付费前请自行鉴别。
3、如文档内容存在违规,或者侵犯商业秘密、侵犯著作权等,请点击“违规举报”。
查找下载文件的指引
一、电脑端
- Windows 系统:按下键盘快捷键 `Ctrl + J`,即可打开下载列表。
- Mac 系统:按下键盘快捷键 `⌘ + J`,即可打开下载列表。
二、手机端
1. 打开手机浏览器,点击浏览器右下角的 “≡”(或“更多”)图标。
2. 在弹出的菜单中找到并点击 “下载内容”(或类似选项),即可查看已下载的文件。
提示:不同浏览器界面略有差异,若未找到“下载”入口,可尝试在浏览器设置中搜索“下载”关键词。